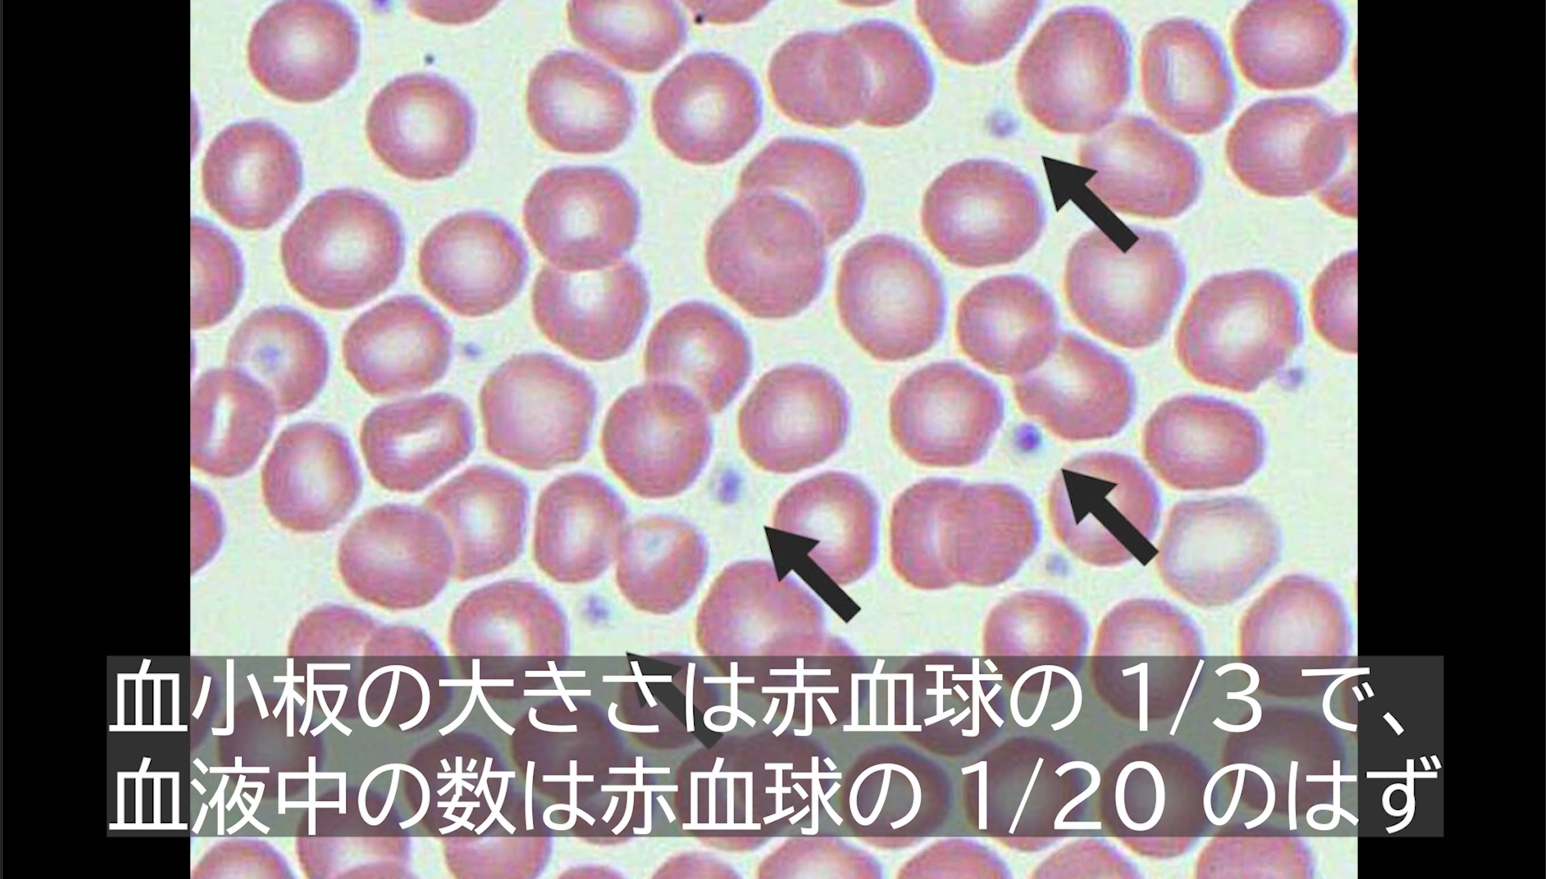
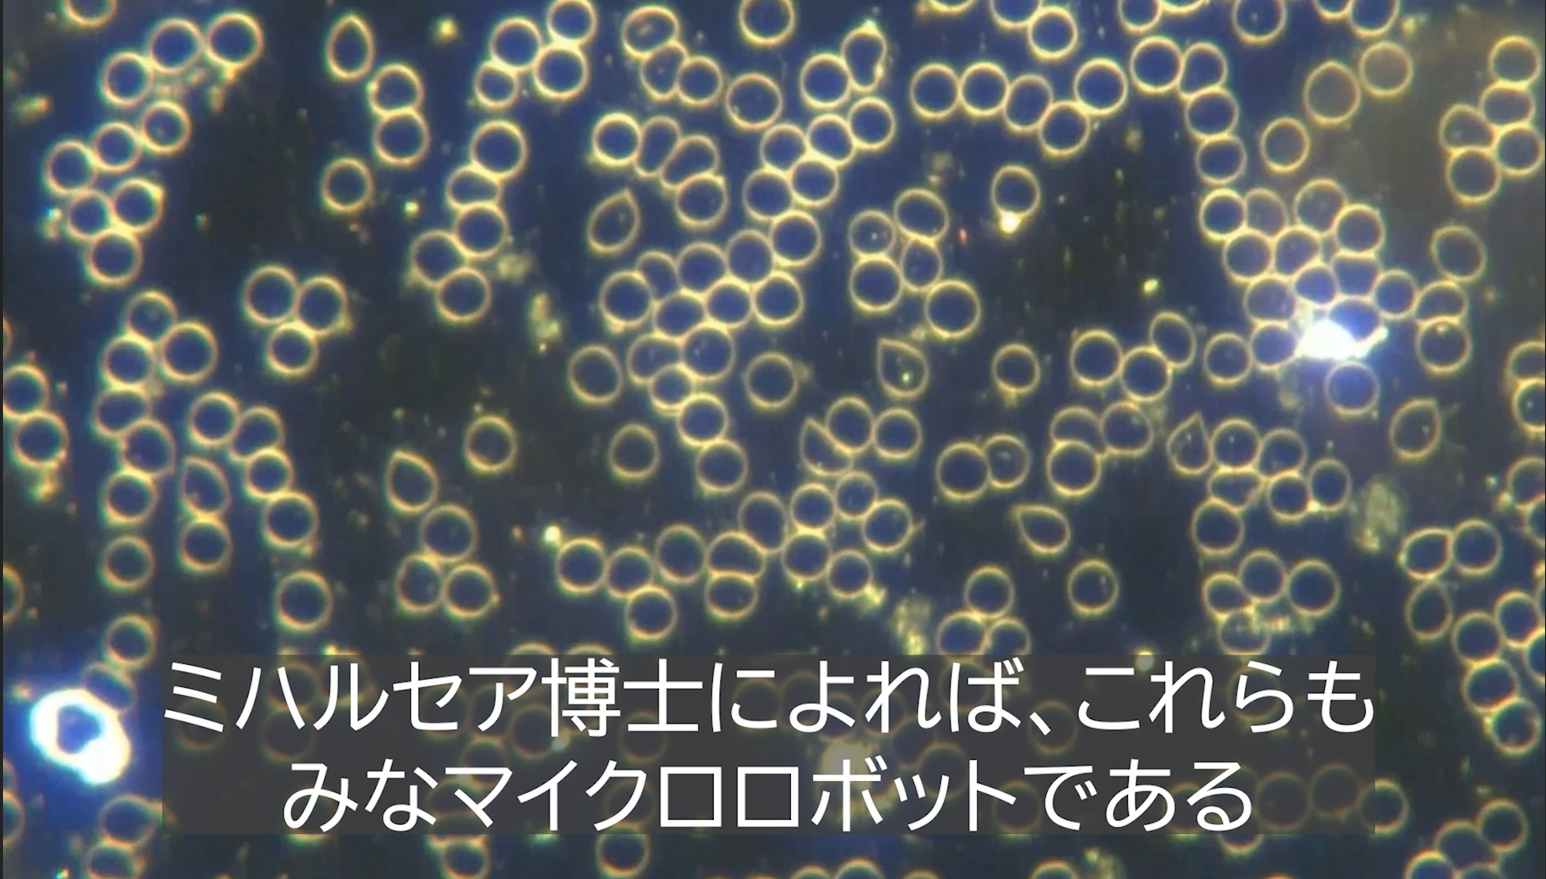

以下はミハルセア博士の1月6日の記事である。文中太字は引用者。コメント、追加画像は赤字で加筆した。
原題:Scientists Create Fully Autonomous Micro Robots That Can THINK, Swim, Swarm In Groups and Survive For Months On Light 科学者たちは、考え、泳ぎ、群れをなし、光だけで何ヶ月も生きられる完全自律型マイクロロボットを開発しました
アナ・マリア・ミハルセア医学博士

引用者追加画像
1月6日


人類はテクノクラート・トランスヒューマニスト計画にまた一歩近づいています。この計画では、ナノロボットやマイクロロボットが感知機能を果たすだけでなく、レイ・カーツワイルによれば、人類を原子ごとに置き換えるという目標が掲げられます。
引用者追加画像
これらの新型ロボットの何がそんなに特別なのでしょうか?それは、完全に自律的で、完全なコンピュータシステムを内蔵し、自ら考えることができるのです!秘密軍事計画DARPAにおける科学は、私たちが信じさせられているよりもはるかに進んでいることが分かっています。実際、故人となったエンジニア、フィル・シュナイダー氏のような米国政府の内部告発者の証言を考慮すれば、1944年以降、秘密プロジェクトは毎年45年ずつ進歩してきたと推定されます。

つまり、秘密政府は私たちよりも約3690年も知識が進んでいるということです。シュナイダー氏は2000年代初頭、これらの秘密政府の周期表には140種類の元素が含まれていることを明らかにしました。一方、私たちの周期表には現在118種類しかありません。もしこれらの情報がすべて公開されたら、科学はどのように変化するでしょうか?
引用者追加画像
私がこのことを言及するのは、未来学者たちが何十年も前から未来に何が起こるかを予測してきたからです。これはもはやSFではなく、政府の指導者でさえ、時間の操作、つまりタイムトラベルが可能だと認めています。
ホワイトハウスは「時間と空間を操作できる」技術を持っていると発表
私が言いたいのは、民間の科学文献で明らかにされている情報は、実際に利用可能な技術から数十年、あるいは数世紀も遅れているということです。自律思考マイクロロボットが主流の文献に登場したという事実は、私たちに考えさせられる材料を与えてくれるはずです。
私(ミハルシア博士)は数年前から、COVID19ワクチン未接種の人間の血液に配備された高度なマイクロロボットを公開してきました。それらは完全に自律的で、光を介して通信し、群がる能力を持っています。
血管内はナノテク工場?忙しく動くマイクロロボット、構築されるフィラメント

当動画は最下段でさらに紹介している。

「シンギュラリティは近づく ― 人間とAIが融合するとき」レイ・カーツワイル著。ナノロボットが私たちの体のすべての細胞を置き換え、ゾンビが出現し、私たちの脳とAIが融合する。C19 ワクチン未接種血液中のナノ/マイクロロボットの驚くべき暗視野生血液映像。レイ・カーツワイルはナノロボットとシンギュラリティについて何を語ったのか?
引用者追加画像
こちらがその記事です:
科学者たちは塩粒よりも小さく、思考できるロボットを開発した
研究者たちは、目に見えないほど小さな極小ロボットを開発しました。しかし、ロボットは感知、判断、そして完全に自律的に移動できるほど賢く、光で動きます。光で動き、小型コンピューターを搭載したこのロボットは、可動部品ではなく電界を操作することで泳ぎます。温度変化を感知し、プログラムされた経路をたどり、さらには集団で協力して作業することも可能です。この画期的な成果は、この極小スケールで真に自律的なロボットが誕生した初めての事例となります。
ペンシルベニア大学とミシガン大学の研究者たちは、これまでに作られた中で最も小型の、完全にプログラム可能な自律型ロボットを開発しました。これらの極小の機械は、液体中を泳ぎ、周囲の環境を感知し、自律的に反応し、一度に数ヶ月間稼働することができ、1台あたり約1セントで製造できます。
各ロボットは拡大しないとほとんど見えず、大きさは約200×300×50マイクロメートルです。つまり、塩粒よりも小さいと言えます。多くの生きた微生物と同じスケールで機能するため、将来的には医師が個々の細胞をモニタリングしたり、エンジニアが高度な製造工程で使用される小型デバイスの組み立てを支援したりするのに役立つ可能性があります。
●医学界で特に有望視されているのは患部への「薬剤送達」である。
完全に光で動くロボットには、プログラムされた経路をたどり、局所的な温度変化を検知し、それに応じて動きを調整することを可能にする微小なコンピューターが内蔵されている。
●血管内に光線の照射が可能かどうかについては、この記事では言及がない。
この研究は、Science Robotics誌および米国科学アカデミー紀要(PNAS)に報告されました。従来の小型ロボットとは異なり、これらのロボットは配線、磁場、外部制御に依存しません。そのため、このような小型ロボットとしては初めて、真に自律的でプログラム可能なロボットとなっています。
「私たちは自律型ロボットを1万分の1の大きさにしました」と、ペンシルベニア工科大学の電気・システム工学助教授であり、本論文の筆頭著者でもあるマーク・ミスキン氏は述べている。「これにより、プログラム可能なロボットの全く新しいスケールが拓かれるのです。」
ロボットの小型化がなぜ難しいのか
電子機器は過去数十年にわたって着実に小型化してきましたが、ロボット工学はそうではありません。ミスキン氏によると、1ミリメートル未満の大きさでの自立動作は未解決の課題のままです。「1ミリメートル未満の大きさで自立動作するロボットを作るのは非常に困難です」と彼は言います。「この分野は実質的に40年間、この問題で行き詰まっています。」
日常的なスケールでは、物体の体積に依存する重力や慣性といった力によって動きが形作られます。しかし、ミクロなサイズになると、表面に関連する力が支配的になります。抵抗と粘性が圧倒的になり、動きの仕組みが劇的に変化します。「体が小さければ、水を押すことはタールを押し通すようなものです」とミスキンは言います。
この物理的変化により、従来のロボット設計は失敗に終わります。小さな腕や脚は壊れやすく、製造が非常に困難です。「非常に小さな脚や腕は壊れやすいのです」とミスキン氏は説明します。「また、製造も非常に困難です。」
これらの限界を克服するために、研究者たちは、ミクロの世界の物理法則に逆らうのではなく、その物理法則を利用してロボットを動かすまったく新しい方法を開発した。
微小ロボットの泳ぎ方
魚などの大型遊泳動物は、ニュートンの第三法則に基づき、水を後方に押し出すことで前進運動を生み出します。しかし、小型ロボットは全く異なるアプローチを採用しています。
ロボットは曲げたり屈曲したりする代わりに、電界を発生させ、周囲の液体中の荷電粒子を優しく押し出します。イオンが移動すると、近くの水分子も一緒に引きずり込み、ロボットの周囲の流体に効果的に動きを生み出します。「まるでロボットが流れる川の中にいるかのようです」とミスキン氏は言います。「しかも、ロボットが川を動かしているのです。」
この電界を調整することで、ロボットは方向転換や複雑な経路の追跡、さらには魚群のような集団で協調して移動することが可能となり、1秒間に体長1つ分の速度に達することができます。上掲の動画ではナノロボットがかなりのスピードで移動する場面がある。
●上掲の動画ではかなりのスピードでマイクロロボットが移動する。「1秒間に体長1つ分」どころではない。
この遊泳法は可動部品のない電極を使用するため、ロボットは驚くほど耐久性に優れています。ミスキン氏によると、マイクロピペットを使ってサンプル間を繰り返し移動させても損傷はありません。LEDの光で駆動するロボットは、数ヶ月間も遊泳を続けることができます。
●体内や血管内でのエネルギー源としてのLED光線がどのように照射されるかについては説明がない。
微小な体に知性を詰め込む
真の自律性には、単なる移動以上のものが求められます。ロボットは周囲の環境を感知し、判断を下し、自ら電力を供給できなければなりません。これらすべての構成要素は、わずか数ミリメートルのチップに収まらなければなりません。この課題に、ミシガン大学のDavid Blaauw氏のチームが挑みました。
ブラウ氏の研究室は既に世界最小のコンピューターを開発した記録を保持している。5年前、国防高等研究計画局(DARPA)のプレゼンテーションでブラウ氏とミスキン氏が出会った時、二人はすぐに互いの技術が互いに補完し合うことに気づいた。「ペンシルベニア工科大学の推進システムと私たちの超小型電子コンピューターは、まさに相性が良いと感じました」とブラウ氏は語る。しかし、そのアイデアを実際に動くロボットにするには、5年の開発期間を要した。
最大の障害の一つは電力だった。「電子機器にとって最大の課題は、ソーラーパネルが非常に小さく、発電量がわずか75ナノワットしかないことです」とブラウ氏は語る。「これはスマートウォッチの消費電力の10万分の1以上です。」システムを機能させるために、チームは極めて低い電圧で動作する特殊な回路を設計し、消費電力を1000分の1以上削減した。
スペースも大きな制約の一つでした。ソーラーパネルがロボットの表面の大部分を占め、コンピューティングハードウェアのためのスペースはほとんど残っていません。この問題を解決するため、研究者たちはロボットのソフトウェアの動作を再設計しました。「コンピュータープログラムの命令を根本的に考え直す必要がありました」とブラウ氏は説明します。「従来は推進制御に多くの命令を必要としていたものを、1つの特別な命令に凝縮することで、プログラムの長さをロボットの小さなメモリスペースに収まるようにしました。」
感知しコミュニケーションするロボット
これらの進歩により、研究者たちは、真の意思決定能力を持つ初のサブミリメートルロボット(1ミリ以下のサイズ、マイクロレベルのサイズ)が誕生したと考えています。彼らの知る限り、これほど小さなロボットにプロセッサ、メモリ、センサーを備えた完全なコンピュータを搭載した例は他にありません。この成果により、ロボットは周囲の環境を感知し、自律的に反応することが可能になりました。
ロボットには、摂氏0.3分の1度という小さな変化も検知できる電子温度センサーが搭載されています。この機能により、ロボットはより温かい領域へ移動したり、細胞活動の指標となる温度値を報告したりすることができ、個々の細胞をモニタリングすることが可能になります。
これらの測定値を伝達するには、独創的な解決策が必要でした。「温度測定値を報告するために、ロボットが行う小さなダンスの小刻みな動きの中に、測定温度などの値をエンコードする特別なコンピュータ命令を設計しました」とブラウ氏は言います。「そして、カメラ付きの顕微鏡でこのダンスを観察し、その小刻みな動きからロボットが私たちに何を伝えようとしているのかを解読します。これは、ミツバチ同士がコミュニケーションをとる方法と非常によく似ています。」
ロボットに電力を供給するのと同じ光が、プログラミングにも使用されます。各ロボットには固有のアドレスが割り当てられているため、研究者は異なるユニットに異なる指示をアップロードできます。「これにより、さまざまな可能性が開かれます」とブラウ氏は付け加えます。「各ロボットが、より大きな共同タスクにおいて異なる役割を果たす可能性も秘めています。」
将来の微小機械のためのプラットフォーム
現在のロボットは単なる出発点に過ぎません。将来のバージョンでは、より高度なプログラムを搭載し、より高速に動作し、追加のセンサーを搭載し、より過酷な環境で動作できるようになる可能性があります。研究者たちは、堅牢な推進方式と、安価に製造でき、時間の経過とともに適応できる電子機器を組み合わせた、柔軟なプラットフォームとしてシステムを設計しました。
「これはほんの始まりに過ぎません」とミスキンは語る。「目に見えないほど小さなものに脳、センサー、モーターを搭載し、何ヶ月も動作させられることを実証しました。この基盤(プラットフォーム)ができれば、あらゆる知能や機能を積み重ねていくことができます。これは、マイクロスケールのロボット工学に全く新しい未来への扉を開くのです。」
血管内はナノテク工場?忙しく動くマイクロロボット、構築されるフィラメント

Gemini もまともに答えられないマイクロロボットの現実

この動画では赤血球よりもはるかに小さい物体が赤血球よりもたくさんうごめいている。AI はこれを説明できないので、強引に「血小板だ」と決めつける。(笑)もっと大きい発光するマイクロロボットは「白血球」だと決めつける始末。(笑)

血管内はナノテク工場?忙しく動くマイクロロボット、構築されるフィラメント




コメント